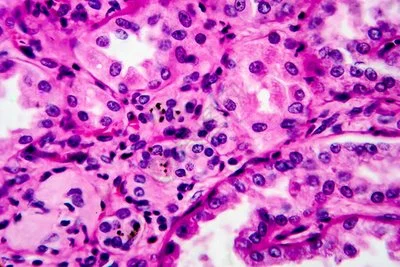
blog-400-267

Is Gotu Kola Powder Good for Kidneys?
The plant Centella asiatica, which is used to make gotu kola powder, can help keep your kidneys healthy by reducing inflammation and protecting cells from damage. Researchers say that bioactive chemicals like asiaticoside and madecassoside may help the kidneys work better by reducing harmful stress and inflammation. People have used this plant to treat a wide range of health issues for a very long time. New studies show that it may also help keep kidney cells healthy and make blood flow better. For now, people with kidney issues should not use it until they talk to their doctor. This is because the study is still new and needs more clinical support

English name: Gotu Kola Extract
Latin Name:Centella Asiatica(L.) Urban
Active ingredients: asiaticoside
Specification: 10%-90%
CAS No.: 16830-15-2
Molecular forula: C48H78O19
Molecular Weight: 959.12
Use Part : The whole herb
Appearance: Brown-yellow to White Powder
Mesh size:80 Mesh
Test Method: HPLC
Understanding Gotu Kola Powder and Kidney Health
The plant that gotu kola powder comes from is called Centella asiatica. This flower blooms once a year and is in the Apiaceae family. It does well in wet places in Asia, Africa, and Madagascar. Getting all the parts of flying plants together carefully is the first step in making them. The plants are then dried and put through a very fine grinder to keep their valuable medicinal chemicals. There are five-ringed triterpenoids in this group, such as asiaticoside, madecassoside, asiatic acid, and madecassic acid. They work together to make the plant useful for medicine.
Bioactive Components Relevant to Kidney Function
All together, the standardized extract usually has at least 40% triterpenoids, and the amount of asiaticoside in good items can reach 10% or more. These chemicals are very stable when they are treated with cutting edge high-temperature drying and ultra-fine grinding technology. Because of how their molecules are built, these triterpenoids can work with cell processes that reduce swelling and heal tissues. Due to this, they are very good for kidney health.
Kidney Function and Common Health Challenges
Some of the most important things the kidneys do are clear the blood, keep the body's chemicals in balance, and get rid of waste. About 120 to 150 quarts of blood are filtered out of the body every day by these organs. They get rid of dangerous substances while keeping healthy proteins and nutrients. A lot of people around the world have common kidney illnesses like nephritis, diabetes nephropathy, and chronic kidney disease. In business-to-business markets, this makes a big need for green goods that can help.
Traditional Ayurvedic and Chinese medicine systems have utilized Centella asiatica for centuries to support various organ systems, including those involved in fluid regulation and detoxification. Modern applications in functional foods and nutraceuticals build upon this historical foundation while incorporating contemporary scientific understanding of the herb's mechanisms of action.
Scientific Evidence and Health Benefits of Gotu Kola Powder for Kidneys
A new study suggests that gotu kola powder may be good for your kidneys in more than one way. Pro-inflammatory cytokines and nuclear factor-kappa B are stopped from being made, which makes it anti-inflammatory. Asiaticoside has been shown in studies to lower inflammation markers in kidney cells. This could help people with long-term inflammation diseases that hurt kidney function get better more slowly.
Antioxidant Protection for Kidney Cells
Because they are antioxidants, chemicals in gotu kola help get rid of reactive oxygen species that can hurt kidney cells. Researchers have found that madecassoside is a powerful antioxidant that keeps kidney cells from getting hurt by reactive stress. There is a chance that this protection effect will help people who breathe in toxins or have metabolic problems that make the kidneys work harder because of reactive stress.
Circulatory Enhancement and Renal Blood Flow
Given that gotu kola can improve circulation, it can also help the kidneys work better by increasing blood flow to them. Vasoprotective parts of the plant help keep kidney blood vessels healthy. This makes sure that nephrons get enough blood flow. Researchers have found that people who regularly take gotu kola supplements have better microcirculation. But these benefits for kidney health need to be proven in bigger studies with real people.
Safety Considerations and Research Limitations
People generally like gotu kola, but it might not work well with some medicines, especially ones that change how blood clots or how the liver breaks down food. As the kidneys change how they work, they may change how the body breaks down plant compounds. People who already have kidney disease should be careful. It's not perfect, but bigger clinical trials with groups of people whose kidneys don't work well are needed to get more long-term safety data and better results on kidney health.
Comparing Gotu Kola Powder with Other Herbal Solutions for Kidney Support
Raw gotu kola powder is not the same as controlled goods when it comes to how bioavailable it is and how well it can be used as medicine. Standardized extracts, like TECA (Titrated Extract of Centella Asiatica), give steady amounts of triterpenoids that are potent. On the other hand, raw powder has many different plant chemicals in different amounts. Extract types usually have higher bioavailability because the active ingredients are concentrated and the body can absorb them better.
Gotu Kola Versus Alternative Kidney Support Herbs
Gotu kola is better for your kidneys than other plants that are good for them in some ways. Cranberry is mostly good for your bladder system. On the other hand, gotu kola helps with inflammation and blood flow, which can make the kidneys work better overall. Gotu kola is different from nettle leaf because it protects cells through its antioxidant properties. The plant is not like herbs that only do one thing; it has adaptogenic qualities that help kidney health in more than one way.
Quality Benchmarks and Certification Standards
When plants are certified organic, it means they were grown without using any man-made herbicides or fertilizers. This is especially important for the health of your kidneys, which remove toxins from your body. Premium service providers follow strict rules when they test for heavy metals, chemical residues, and bacterial toxins. For each batch, standardization to a certain marker chemical makes sure that the strength is the same. This lets business-to-business clients in the pharmacy and nutraceutical industries make formulas that they can trust.
Practical Usage, Dosage, and Preparation for Optimal Kidney Benefits
People usually say to take 500 mg to 1500 mg of standardized extract every day, which is equal to 3 to 6 grams of raw gotu kola powder. This is to help the kidneys. Smaller amounts are generally taken over longer periods of time with traditional recipes. On the other hand, bigger amounts have been taken over shorter times in clinical tests. A box size that keeps its strength and gives you choices for different formulation needs is something to think about when you buy from another business (B2B).
Preparation Methods and Bioavailability Enhancement
You put 1 to 2 grams of powder into hot water and let it sit for 10 to 15 minutes. But this process might not get rid of all the chemicals that dissolve in fat. Encapsulation keeps all kinds of chemicals safe and lets you give exact doses. Adding black pepper extract or phospholipids to gotu kola can help the body use it better. Because of this, these synergistic mixes are good for using in advanced nutrition.
Quality Assurance Throughout the Supply Chain
An important part of checking out suppliers is getting third-party testing certificates and making sure the source follows Good Manufacturing Practice (GMP). To show that each batch is the right one, HPLC fingerprinting should be used. The amount of marker chemicals should also be measured, and the product should be checked for any impurities. If you keep compounds properly, in cool, dry places away from direct light, they will stay stable. Also, nitrogen-flushed packaging stops oxidation during long storage times.
Keeping an eye on the temperature during transport keeps the product's quality safe, which is especially important when moving things across foreign borders. For deals that go across countries, you need to show Certificates of Analysis (COA), Material Safety Data Sheets (MSDS), and, if needed, organic certificates.

Strategic Procurement: How B2B Clients Can Source High-Quality Gotu Kola Powder?
A market study shows that there is a steady rise in the need for standardized plant products. As more people learn about natural health choices and officials become more open to botanical ingredients, this is the case. Most of the time, ordering more than 500 kg will save you a lot of money, and if you sign a yearly supply deal, you can save even more. With logistics optimization, you can lower total costs while keeping effective supply chain management by combining shipping and putting stores in key spots.
Supplier Selection and Risk Mitigation
Reliable providers make sure that the quality is always the same by checking everything thoroughly and keeping clear records of the supply chain. Well-known vitamin and drug company customer reviews can tell you a lot about how reliable a seller is and how well a product works. Brands have images that are shown by things like industry certificates, a past of following the rules, and being a part of professional trade groups.
It's less likely that something bad will happen if you have multiple connections with sellers, stick to quality agreements, and set up backup sources of supplies. Make sure that quality standards are always being met by checking source sites on a regular basis. This also gives you a chance to find ways to make the work better.
Integration Strategies for Product Development
Distributors can use gotu kola powder in specialized formulas for blood flow, brain health, and general fitness. The herb works well with other plants and stays stable in different dose forms, such as drinks made with powder and pills. To get people who care about their health to buy, marketers should talk about both the old ways of using it and the newest scientific proof.
One way to make new products is to mix gotu kola with plants that work well together to get synergistic benefits. Another way is to make custom delivery methods that improve bioavailability. As part of teaching people about the herb, materials should talk about its unique properties as well as how to use it properly and safety issues.
Conclusion
Gotu kola powder may be good for kidney health because it lowers swelling, keeps cells from getting hurt, and raises blood flow. Some standardized bioactive chemicals, like asiaticoside and madecassoside, show promise as ways to protect kidney function and make kidney health better in general. Even though traditional medicine backs up what we already know, a new study is still helping us figure out how this amazing plant makes kidney health better. Business to Business buyers can be sure that when they buy high-quality gotu kola powder, they are getting it from companies that have strong quality systems, thorough testing methods, and a history of success in the plant extract business.
FAQ
Is gotu kola powder safe for people with kidney disease?
In case you already have kidney issues, you should talk to your doctor before taking gotu kola pills. If you want to change the way your kidneys work, it might affect how your body uses plant compounds. Because of this, you should only use them with your doctor's advice.
How long does it take to see kidney health benefits from gotu kola powder?
Traditional use patterns say that after 4 to 8 weeks of regular use, benefits may start to show. However, everyone reacts in their own unique way. People who take part in clinical studies often watch the results for 8 to 12 weeks to see if there are any real changes in health signs.
Can gotu kola powder interact with kidney medications?
It's possible that gotu kola won't work well with blood thinners or drugs that the liver breaks down. People who take prescription drugs should talk to their doctors about any possible drug reactions before adding gotu kola to their workout routine.
Partner with Rebecca for Premium Gotu Kola Powder Supply
The company Shaanxi Rebecca Biotechnology is a good one that makes gotu kola powder. They offer pharmaceutical-grade plant goods that meet the strict requirements of B2B markets around the world. When we process your order, our state-of-the-art facilities use cutting-edge high-temperature drying and ultra-fine grinding technology to keep the biological power at its peak and make sure that each batch has the same quality. We've been making plant products for more than 13 years, so we know how important it is for your business to have a steady supply chain, all the right paperwork, and to follow all the rules.
Our quality assurance protocols include rigorous testing for heavy metals, herbicide leftovers, and microbiological toxins. All the information for these tests comes from the COA and other countries. Because we have a lot of different ways to make things, we can meet the wants of many customers and keep our prices low. This is true whether you need a few samples to test a new product or a lot of them to make a business.
The Rebecca edge comes from our commitment to quality, our skilled know-how, and our service that is centered on you, the customer. contact us at information@sxrebecca.com to talk about your specific needs and find out how our fine gotu kola powder can help you make better products that sell better.
References
1. Chandrika, U.G., & Prasad Kumara, P.A.A. (2015). Gotu kola (Centella asiatica): Nutritional properties and plausible health benefits. Advances in Food and Nutrition Research, 76, 125-157.
2. Hashim, P., Sidek, H., Helan, M.H.M., Sabery, A., Palanisamy, U.D., & Ilham, M. (2011). Triterpene composition and bioactivities of Centella asiatica. Molecules, 16(2), 1310-1322.
3. Nasir, M.N., Habsah, M., Zamzuri, I., Rammes, G., Hasnan, J., & Abdullah, J. (2011). Effects of asiatic acid on passive and active avoidance task in male Sprague-Dawley rats. Journal of Ethnopharmacology, 134(2), 203-209.
4. Somboonwong, J., Kankaisre, M., Tantisira, B., & Tantisira, M.H. (2012). Wound healing activities of different extracts of Centella asiatica in incision and burn wound models: an experimental animal study. BMC Complementary and Alternative Medicine, 12, 103.
5. Bylka, W., Znajdek-Awiژن, P., Studzińska-Sroka, E., & Brzezińska, M. (2013). Centella asiatica in cosmetology. Advances in Dermatology and Allergology, 30(1), 46-49.
6. Gohil, K.J., Patel, J.A., & Gajjar, A.K. (2010). Pharmacological review on Centella asiatica: a potential herbal cure-all. Indian Journal of Medical Research, 132(2), 147-160.
_1730691017423.webp)